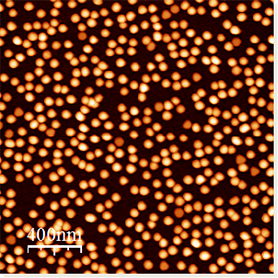

Gymnasieopgaver
Syntese og karakterisering af guld nanopartikler

Gymnasieopgaver
Syntese og karakterisering af guld nanopartikler

Syntese og karakterisering af guld nanopartikler
Gymnasieopgaver

Gymnasieopgaver
Kort beskrivelse af aktiviteten: Metalnanopartikler kan syntetiseres kemisk som en kolloidal opløsning; deres størrelse kan variere fra nanometer til hundrede nanometer. Sådanne nanopartikler har i dag mange anvendelser, lige fra bakteriedræbende overtræk til biologiske mærker og lægemiddelafgivelsessystemer.
I dette forsøg vil en studerende syntetisere guld nanopartikler ved at reducere guldchlorid med citrat. Størrelsesfordelingen af den opnåede nanopartikelopløsning vil blive undersøgt ved Nanoparticle Tracking (NTA) og Atomic Force Microscopy (AFM). Den studerende får AFM-billeder og NTA-størrelsesfordeling til at behandle data med Excel, Maple eller lign. software.
Faglig relevans: Fysik, Matematik, Kemi, Biologi, Bioteknologi, Teknologi
Nøgleord: Nanoparticles, Atomic Force Microscopy, Size Distribution, Histograms, Image Processing
Forberedelse: Redox reaktioner og lys absorption
Tidspunkter for besøget: Kan aftales med kontaktperson
Maks. antal personer: 3-4
Besøgets varighed: 1-2 eftermiddage
Mødested: Aftales med kontaktperson
Kontaktperson: gymnasieportalen@adm.aau.dk Leonid Gurevich, Institut for Materialer og Produktion
Evt. detaljeret beskrivelse / Bilag: